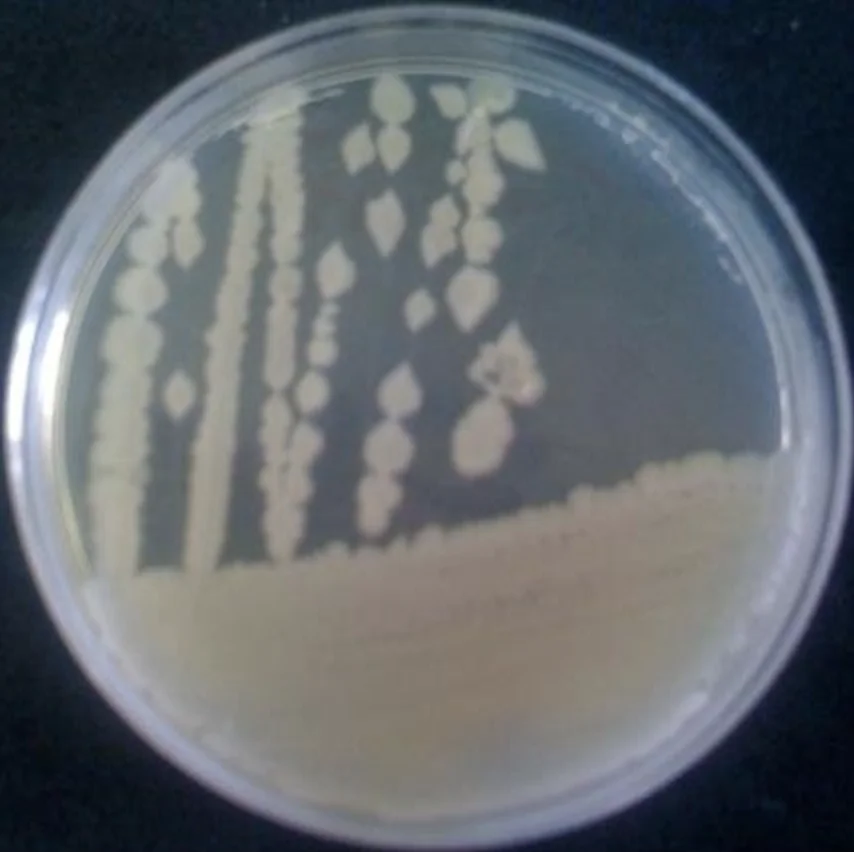
Bacillus Thuringiensis Israelensis Highest Quality 4000 IU/mg 8000IU/mg 16000 IU/mg

Bacillus Thuringiensis Israelensis Highest Quality 4000 IU/mg 8000IU/mg 16000 IU/mg
- Category: >>>
- Supplier: INDO GULF COMPANY
Share on (62004389651):
Product Overview
Description
Bacillus thuringensis (Bt) is a facultative anaerobic, Gram-positive bacterium that forms characteristic protein inclusions adjacent to the endospore. Bt is genetically indistinguishable from Bacillus cereus (Bc). However, Bt has the ability to produce parasporal crystalline inclusions, which are toxic for certain invertebrates, especially species of insect larvae belonging to the insect orders Coleoptera, Diptera and Lepidoptera. The parasporal inclusions are formed by different insecticidal crystal proteins (ICP). The crystals have various shapes (bipyramidal, cuboidal, flat rhomboid, spherical or composite with two crystal types), depending on their ICP composition.
Bacillus thuringiensis serotype israelensis (Bti) is a group of bacteria used as biological control agents for larvae stages of certain dipterans. Bti produces toxins which are effective in killing various species of mosquitoes, fungus gnats, and blackflies, while having almost no effect on other organisms. Indeed, this is one of the major advantages of B. thuringiensis products in general is that they are thought to affect few nontarget species.
1kg/ Al. foil, 5kg/ Al. foil, 10kg/drum, 20kg/carton drum or customized as per requirement.
Shiping service offered by air cargo / sea cargo / door delivery by DHL/Fedex
We offer Custom research and manufacturing services for different Microbial species & Biofertilizers, offering concentrated form of products to blend with your existing formulation.
We also offer Bacillus thuringensis (Bt) var Kurstaki Powder
As a Pioneer in Biological Agri technology, Indogulf BioAg is committed to offering proven and effective biological solutions that enable growers worldwide to help maximize and protect crop production.
Q: Are you trading company or manufacturer ?
A: We are Organic certified Manufacturers specialized in bio-organic, soil conditioner, liquid nutrients, micro fertilizer.
Q: What is the product used for?
A: It can be used for all kinds of plants
Q: How long is your delivery time?
A: We can supply goods within 10 days if goods are in stock. If goods are not in stock its between 2- 3 weeks in accordance to order quantity.
Q: Do you provide samples ? is it free or extra ?
We can offer free samples. Cost of shipping has to be on your account.
Q: What is your terms of payment ?
We Recommend
New Arrivals
New products from manufacturers at wholesale prices